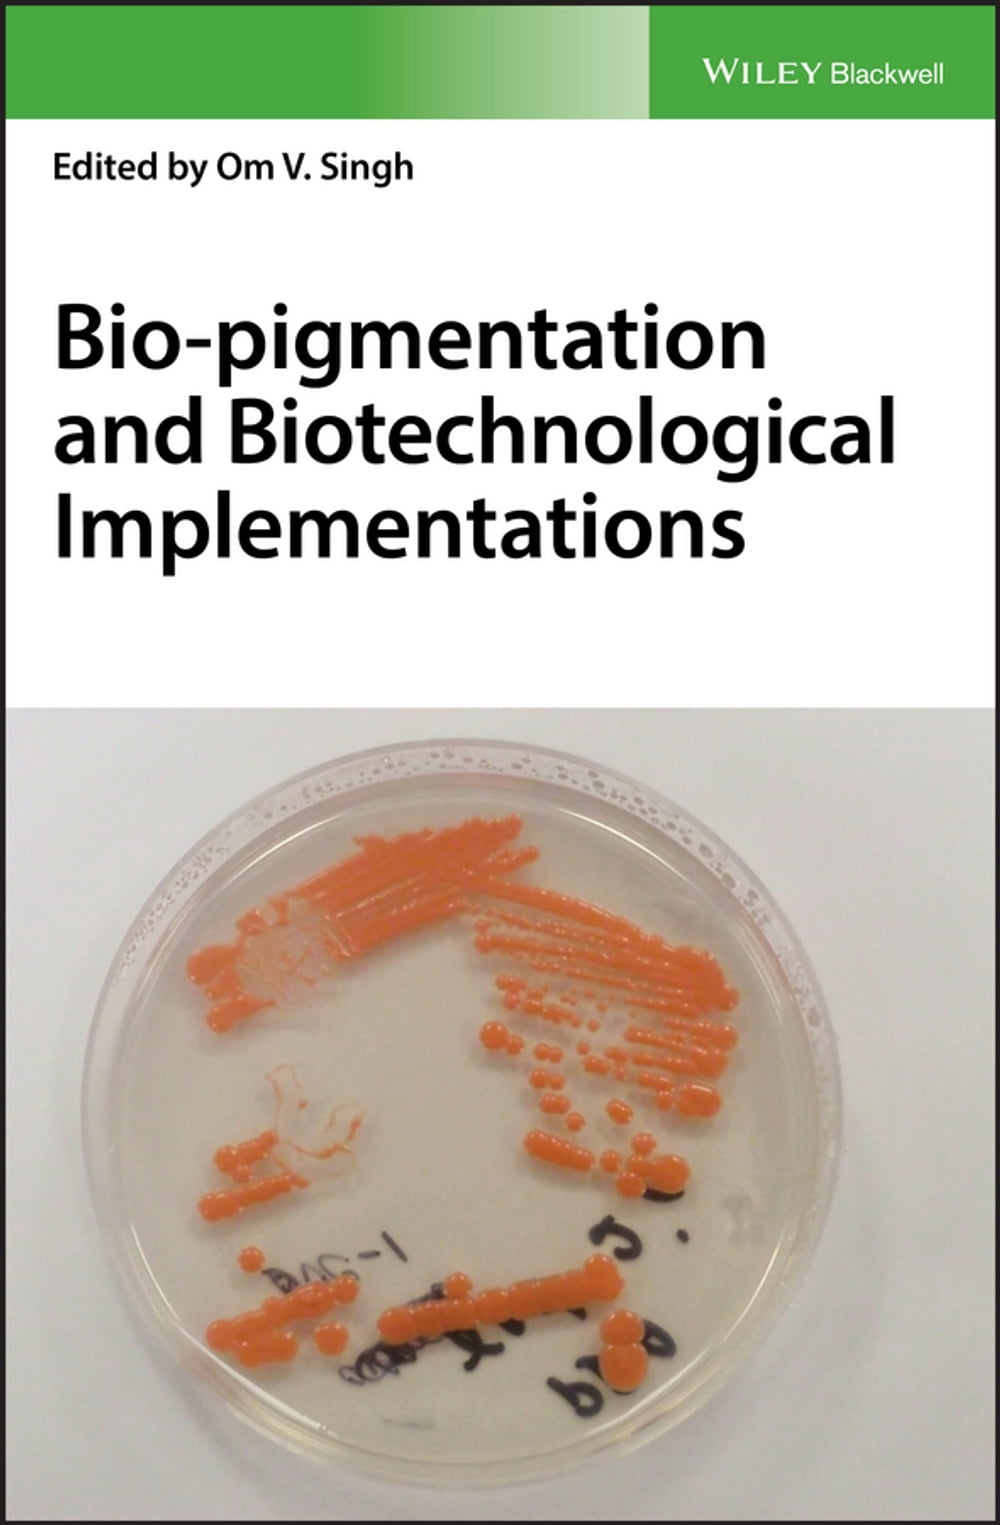
ibs

Bio-pigmentation and Biotechnological Implementations
Recent technological advances have provided unique opportunities for the exploration of alternatives to the industrial use of chemically produced synthetic colors. The most promising developments in this area have been in bio-pigmentation derived from microorganisms. This groundbreaking book reviews the current state of the science of bio-pigmentation, providing important insights into the molecular mechanisms of microbial biosynthesis of industrial pigments. Featuring contributions by leading researchers from both industry and academe, it explores the latest advances in the use of bio-pigments as safe, sustainable alternatives to chemically synthesized pigments, and provides extensive coverage the most promising sources of bio-pigments within the food, feed, and pharmaceutical industries. • Proposes microbial uniqueness of coloration in variety of food, feed and pharmaceuticals • Covers the basic science behind bio-pigmentation as well as the latest advances in the field • Describes detection strategies for screening and identifying color producing microorganisms under varying environmental conditions • Provides an exhaustive review of the literature on color producing extremophiles and offers fascinating insights into color production as a stress response in extremophiles • Explores microbial molecular mechanisms of color production, with special coverage of color production as secondary metabolites under environmental stress Bio-pigmentation and Biotechnological Implementations is required reading for professionals and post-doctoral students of microbiology, applied microbiology, food microbiology, food science, and food biochemistry. It is a valuable working resource for scientists working in color-dependent food, feed, and pharmaceuticals.
-
Curatore:
-
Anno edizione:2017
-
Editore:
-
Formato:
Formato:
Gli eBook venduti da Feltrinelli.it sono in formato ePub e possono essere protetti da Adobe DRM. In caso di download di un file protetto da DRM si otterrà un file in formato .acs, (Adobe Content Server Message), che dovrà essere aperto tramite Adobe Digital Editions e autorizzato tramite un account Adobe, prima di poter essere letto su pc o trasferito su dispositivi compatibili.
Cloud:
Gli eBook venduti da Feltrinelli.it sono sincronizzati automaticamente su tutti i client di lettura Kobo successivamente all’acquisto. Grazie al Cloud Kobo i progressi di lettura, le note, le evidenziazioni vengono salvati e sincronizzati automaticamente su tutti i dispositivi e le APP di lettura Kobo utilizzati per la lettura.
Clicca qui per sapere come scaricare gli ebook utilizzando un pc con sistema operativo Windows